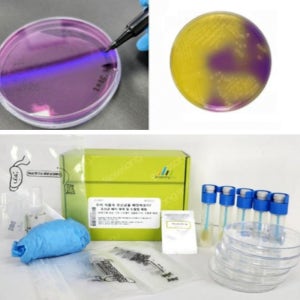
5인용 미생물 유산균 배지만들기 도말법 과학실험교구

- 순위변경4 갤럭시s26
- 순위변경10 갤럭시s26 울트라
- 순위변경6 ddr4 16gb
- 순위변경10 9600x
- 순위변경7 ddr5 32gb
- 순위변경3 갤럭시 탭 s 11 울트라
- 신규진입 로보락 f25 ace
- 신규진입 삼성 85인치 tv
- 순위변경4 gamesir g7
- 순위변경2 필립스 전기 면도기
-
- 급상승 키워드
급상승 키워드- 순위변경4 갤럭시s26
- 순위변경10 갤럭시s26 울트라
- 순위변경6 ddr4 16gb
- 순위변경10 9600x
- 순위변경7 ddr5 32gb
- 순위변경3 갤럭시 탭 s 11 울트라
- 신규진입 로보락 f25 ace
- 신규진입 삼성 85인치 tv
- 순위변경4 gamesir g7
- 순위변경2 필립스 전기 면도기
카테고리에서
상품을 볼 수 있습니다.

-

3,500원
3,500원
네이버페이 에코플레이 ecoplay
별점 4.00리뷰수 (2) -
 구매 10+
구매 10+핫버튼 아기 발사이즈 측정기 사이즈 재기 발크기 재는법
990원
3,000원
핫버튼
별점 4.91리뷰수 (11) -

키재는기계 휴대용키재기 초음파키재기 키재기 키재는법 지헬스 소나
99,000원
무료
링쿠
-
51,770원
4,000원
롯데ON
-

시계 보는 법 배우기 유치원 시간 학습 키즈 대형 가정 교구
8,330원
무료
롯데ON
-

파닉스 플래시 카드 법 단어 데스크탑 달력 영어 학습 플립 교육 장난감
16,610원
무료
롯데ON
상세검색
CM 추천 옵션은 하이라이트로 강조했어요.
제조사/브랜드
배송/가격
상품목록

VS검색은 1~5개 상품까지 비교가
가능합니다.
“VS검색하기” 버튼을
눌러 보관함에 담긴 상품들의 스펙을
비교 할 수 있습니다.







![[ColiFact]총대장균군 효소기질법 키트](https://shopping-phinf.pstatic.net/main_8258902/82589021322.jpg?type=f300)





























![[봄봄북스] 아이만큼 자라는 부모 - 참견하지 않고 집착하지 않는, 부모의 최강 육아법](https://ep-cdn.011st.com/11dims/resize/900x900/quality/75/11src/pd/v2/1/1/8/9/4/9/yURBq/8890118949_B.webp)

![[봄봄북스] 셀프 성장 육아법](https://ep-cdn.011st.com/11dims/resize/900x900/quality/75/11src/pd/v2/2/6/6/9/1/7/cJQvL/8951266917_B.webp)





![[예문아카이브] 조금 느린 아이를 위한 발달놀이 육아법](https://ep-cdn.011st.com/11dims/resize/900x900/quality/75/11src/product/7751511701/B.jpg?228000000)



